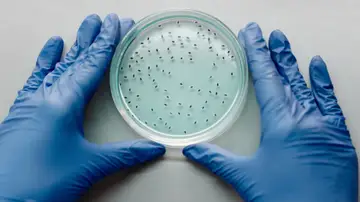

El principio activo y el fármaco son términos sinónimos en este contexto. Se refieren a la sustancia o conjunto de sustancias que tienen un efecto terapéutico en el cuerpo humano. El principio activo es responsable de la acción farmacológica, es decir, es la parte del medicamento que interactúa con el organismo para tratar, prevenir o diagnosticar una enfermedad. Ejemplos de principios activos son el omeprazol, ibuprofeno, paracetamol, fentanilo y simvastatina. El principio activo es el componente esencial del medicamento, ya que es el que ejerce la acción deseada en el tratamiento de una condición médica.
El medicamento es el producto completo que contiene el principio activo (o fármaco) junto con otros componentes llamados excipientes. Los excipientes son sustancias que no tienen actividad terapéutica directa, pero desempeñan funciones cruciales en la formulación del medicamento. Estas funciones pueden incluir facilitar la absorción del principio activo, prolongar su estabilidad, mejorar su sabor o permitir una administración más cómoda.
Un medicamento se administra para restaurar, corregir o modificar las funciones fisiológicas del cuerpo, ejerciendo una acción farmacológica, inmunológica o metabólica. También puede ser usado para establecer un diagnóstico médico.
Diferencias clave

- Principio Activo (Fármaco): Es la sustancia que ejerce el efecto terapéutico. Es el ingrediente esencial que trata la enfermedad o condición.
- Medicamento: Es el producto final que contiene el principio activo y los excipientes. Es lo que se dispensa en las farmacias y se administra a los pacientes.
Cuando un médico prescribe un tratamiento, normalmente indica el principio activo en lugar de un nombre comercial específico. Esto permite al farmacéutico elegir entre diferentes laboratorios que producen medicamentos con el mismo principio activo, siempre que estos medicamentos sean bioequivalentes, es decir, que presenten una biodisponibilidad similar cuando se administran en las mismas dosis y condiciones.
Importancia de la bioequivalencia
La bioequivalencia asegura que dos medicamentos con el mismo principio activo tengan el mismo efecto en el cuerpo, aunque puedan tener diferentes excipientes o sean fabricados por diferentes laboratorios. Esto es fundamental para la seguridad del paciente, ya que garantiza que los medicamentos genéricos sean tan efectivos y seguros como los de marca.